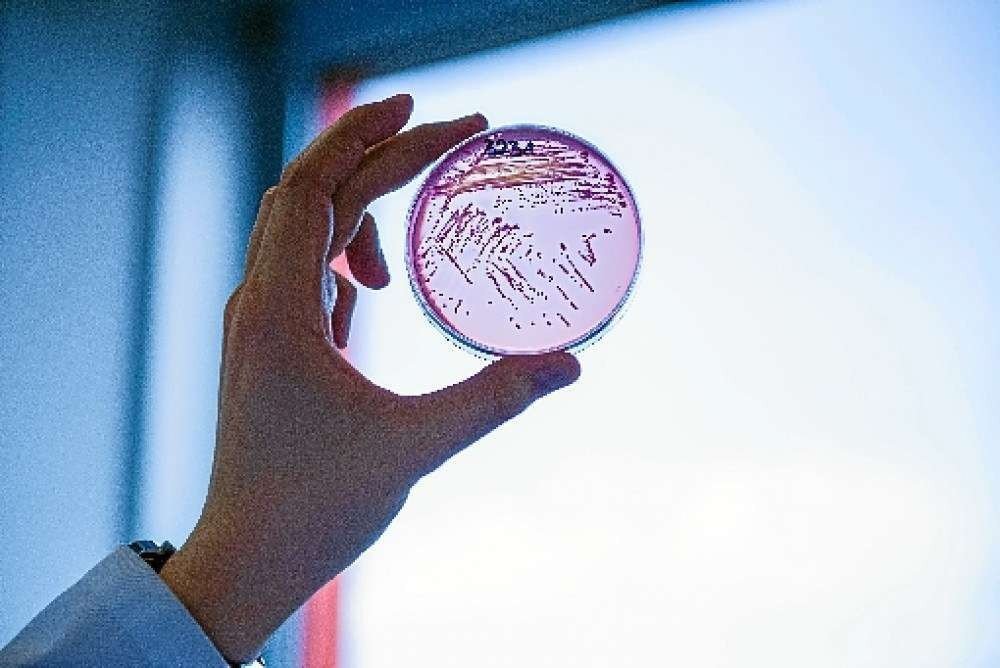

O diretor do Instituto Butantan, Dimas Covas, informou nesta segunda-feira (8/2), que a vacina CororaVac, desenvolvida pela Sinovac em parceria com o instituto paulista, está sendo testada contra a variante do novo coronavírus originária no Amazonas (AM). Covas indicou que em breve o Butantan terá esses resultados, mas o diretor acredita que a possibilidade do imunizante não ter resposta quanto à nova cepa é “bem menor”, já que a CoronaVac é uma vacina de vírus inativado.
Ao ser questionado sobre a possibilidade da CoronaVac ser menos eficaz contra as novas variantes, como é o caso da vacina de Oxford/AstraZeneca — que demonstrou, segundo um estudo, ter eficácia limitada contra a variante sul-africana —, Covas disse que as vacinas de vírus inativado, caso da vacina do Butantan, já mostraram um bom desempenho em relação às novas cepas.
“Essa é uma preocupação de todas as vacinas, mas, principalmente, daquelas vacinas que têm uma única proteína como antígeno, que é chamada de proteína S. De fato, essas vacinas têm apresentado um desempenho inferior, principalmente, com essa cepa sul-africana. Não é o caso das vacinas de vírus inativado. Já tem teste quanto a essas duas variantes, a variante inglesa e da África do Sul, que mostraram um bom desempenho”, afirmou.
África do Sul
No último domingo (7), o governo da África do Sul suspendeu a aplicação da vacina de Oxford/Astrazeneca, no Brasil produzida pela Fundação Oswaldo Cruz (Fiocruz), depois que dados mostraram que duas doses da vacina dariam uma “proteção mínima” contra casos leves e moderados da covid-19 oriundos da variante identificada primeiro naquele país.
Com isso, o diretor do Butantan informou que já é avaliada a eficácia da CoronaVac contra a variante amazônica, para que se descubra se ela é menos eficaz contra essa nova cepa. Ele ressaltou que as vacinas usadas nesses testes contra a cepa do Amazonas são do estudo clínico e não têm relação com os imunizantes que foram distribuídos ao Sistema Único de Saúde (SUS).
“Brevemente teremos esses resultados e acreditamos que, pela própria forma como a vacina é produzida, essa possibilidade de não ter a resposta é bem menor”, avaliou Covas.
Saiba Mais
Notícias pelo celular
Receba direto no celular as notícias mais recentes publicadas pelo Correio Braziliense. É de graça. Clique aqui e participe da comunidade do Correio, uma das inovações lançadas pelo WhatsApp.
Dê a sua opinião
O Correio tem um espaço na edição impressa para publicar a opinião dos leitores. As mensagens devem ter, no máximo, 10 linhas e incluir nome, endereço e telefone para o e-mail sredat.df@dabr.com.br.
 Brasil
Brasil
Brasil
Brasil